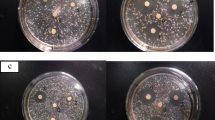

Abstract
The aim of the study was to investigate the influence of microencapsulation by spray drying on fish oil sensory quality. Evaluated fish oil powders were coated with modified cellulose, skim milk powder and a mixture of fish gelatin and cornstarch. Samples were stored in the presence of air and under vacuum and then sensory evaluated. It was shown that fish oil powders were very susceptible to oxidation resulting in off-flavor formation. Odor profiles of samples stored in the presence of air were unstable and showed increases in undesirable odor attributes, which were significantly correlated with peroxide value, especially in the case of samples formed by spray drying. Elimination of air from the packaging improved stability of all samples during storage in both odor profile and peroxide value. The main conclusion of this study is that microencapsulation, especially by spray drying, provokes strong changes in fish oil sensory quality. Microencapsulated fish oil powder is not stable and rapidly oxidizes in the presence of air. However, its stability may be improved when stored under vacuum.
Similar content being viewed by others
Avoid common mistakes on your manuscript.
Introduction
It is well established that polyunsaturated omega-3 fatty acids positively influence human health. In many studies, it has been shown that long chain omega-3 fatty acids (LC PUFA) decrease the risk of cardiovascular diseases, some types of cancer, and autoimmune disorders. Moreover, omega-3 LC PUFA positively impact the proper development and function of the central nervous system as well as visual properties [1, 2]. The main omega-3 LC PUFA are eicosapentaenoic and docosahexaenoic acids (EPA C20:5 and DHA C22:6), and their richest dietary source is sea fish, e.g., herring, tuna, cod, menhaden, etc., especially fish oils.
Because of a positive influence on human health, an increase of omega-3 LC PUFA intake is currently strongly recommended. It is usually recommended to have at least two servings of fatty fish per week, which is approximately equivalent to 1.5 g of EPA plus DHA, i.e., 0.2 g per day [3]. Nevertheless, some organizations recommend higher intakes, e.g., the International Society for the Study of Fatty Acids and Lipids proposed an adequate intake of EPA plus DHA to be 0.65 mg per day and even more in the case of pregnant and lactating women [2]. Nevertheless, the average level of omega-3 LC PUFA intake with the Western style diet is much lower—approximately 0.15 g per person per day [3, 4].
It is obvious that elevation of omega-3 LC PUFA intake may be achieved by regular consumption of fish. However, it can be also achieved by the intake of fish oil supplements or foods enriched with fish oil in liquid or powder form, which can be obtained by microencapsulation [3, 5]. However, due to very high level of omega-3 LC PUFA unsaturation, fish oil is extremely susceptible to oxidation. Thus, when incorporated into food products, the main concern is oxidative deterioration provoking subsequent development of unacceptable fishy off-flavors [6]. Microencapaulation is believed to protect fish oil against oxidation by limiting undesirable influences of the environment, i.e., oxygen, light, humidity, etc., [3, 7]. A number of companies have created microencapsulated fish oil powders for use in the food industry. However, quality assessment of fish oil and fish oil powders, as well as of fish oil-containing foods, requires adequate methods, both chemical and sensory. Convenient and sensitive sensory methods, which enable precise detection of flavor differences in food samples, are discriminatory methods, e.g., duo-trio test [8]. Additionally, sensory evaluation of specific off-flavors enables accurate perception and measurement of fish oil oxidative deterioration over time [8]. Quantitative descriptive analysis (QDA) was successfully used for description and assessment of the flavor profiles of fish oil-containing foods, as well as their changes during storage [9].
Microencapsulation of fish oil produces a dry powder from liquid fish oil, which enables its use for the enrichment of instant foods, formulae, bread, etc., in order to deliver omega-3 LC PUFA to the diet [3, 5]. During the microencapsulation process, fish oil micro droplets are coated with materials creating the wall of the microcapsules. There are a number of techniques used for fish oil microencapsulation, the method with the lowest costs being spray drying; other techniques are fluidizing bed, freeze-drying and double coating. Keogh et al. [10] as well as Hogan et al. [11] reported the successful use of spray drying for fish oil microencapsulation using materials of milk origin as coating agents. Various hydrocolloids are used as coating materials, including combinations of gelatin, maltodextrin or other carbohydrates, starch etc., as well as plant gums (acacia, alginate), skimmed milk powder and milk proteins [7, 10, 12–14].
Microencapsulated fish oil powder is usually considered as an easy delivery system of omega-3 LC PUFA to the food and human diet [3, 5, 15]. In industrial practice, in order to diminish off-flavor detection, small amounts of fish oil and an extra addition of flavorings or seasonings are added to fish oil enriched foods, as well as antioxidants, especially of natural origin like flavonoids or carotenoids [3, 7]. These last may effectively mask unacceptable off-flavors formed during gradual oxidation of fish oil in enriched foods, when processed and stored pervious to air. Such practise makes fish oil-enriched foods palatable for longer. However, masked fish oil oxidation impacts the safety of enriched foods and may be harmful to the consumer’s health [5]. Moreover, it has been reported that some antioxidants used for stabilization against oxidation may paradoxically accelerate fish oil oxidation under certain conditions, especially when emulsified in complex food systems [6, 16].
Many studies have shown that quality control of fish oil-containing foods needs not only an assessment of the present oxidation status of the product but also of its oxidative stability during storage [17, 18]. It is obvious that sensory quality of foods is the most important aspect for the consumers, with flavor a crucial sensory discriminator [8]. Association of specific off-flavors to particular volatile compounds formed during oxidation of fish oil (as well as other fats) enables precise perception and measurement of lipid oxidation processes. This may significantly improve quality control of fish oil and fish oil-containing foods. The results of sensory evaluation are strongly related to the level of fish oil enrichment. When the enrichment level is very low, it is almost impossible to detect it by sensory methods, or to detect possible off-flavors formed during storage by oxidation of fish oil added to the foods (in liquid or powder form), especially when processing, storage and distribution conditions were inappropriate, e.g., air and light access and elevated temperatures [5, 6].
It is well established that the sensory threshold values of volatile compounds responsible for off-flavor formation during oxidation of fish oil are much lower when the surface area is highly developed [6, 19]. Thus, if fish oil is emulsified, off-flavor compounds’ volatility is higher than the volatility of the same compounds in bulk fish oil [6, 19]. The first step in the microencapsulation of fish oil is the preparation of the emulsion of coating materials and fish oil. Jacobsen [6] as well as Heinzelman et al. [12] reported that the exposure of fish oil to air during preparation of the emulsion leads to an acceleration of oxidation of fish oil even before the drying process [6]. The hypothesis for this study was that microencapsulation, especially by spray drying, results in a decrease of fish oil stability, both chemical and sensory ones. Hence, the aim of the study was to investigate the influence of microencapsulation by spray drying on fish oil sensory quality.
Experimental Procedures
Materials
Purified and stabilized fish oil, Ropufa‘30’n-3 Food Oil (DSM Nutritional Products, Switzerland), was used for the preparation of all spray-dried samples. The fish oil used was a yellowish, oily liquid with a very faint, fish-like odor. Initial peroxide value of the oil was 1.05 mEq of active oxygen per 1 kg, and omega-3 LC PUFA content was approximately 300.0 g kg−1. Methylcellulose (MC), Methocel A15 (Dow Chemical, USA), was used as the main coating material for sample A preparation. Dextrin (National Starch & Chemical, USA) was used as an additional coating agent. Lecithin-3-sn-phospatidylcholine from soybean (Fluka, Germany) was used as an additional emulsifier to improve the homogenization process for the preparation of sample A. Skim milk powder was obtained from TSI & KG (Germany). Microencapsulated fish oil, Ropufa‘10’n-3 Food Powder, was given as a grant by DSM Nutritional Products (Switzerland). It was a pale brownish powder containing the mentioned above fish oil dispersed in a matrix of fish gelatin, cornstarch, and saccharose; omega-3 LC PUFA content was approximately 100.0 g kg−1.
Sample Preparation
Sample A was obtained by spray drying of the prepared emulsion of fish oil and coating materials. The dextrin was dissolved in cold deionized water by gentle magnetic stirring, and then the methylcellulose solution was added and mixed using a hand blender at 200 rpm (Braun, Germany). An aqueous suspension of lecithin was prepared using a heated magnetic stirrer. The coating materials solution was magnetically mixed for 30 min and chilled in an ice bath to 5 ± 0.5°C. Fish oil and lecithin suspension were poured into the prepared solution under stirring. Obtained coarse emulsion was homogenized in an ice-water bath using laboratory homogenizer Ultraturax TK 25 (IKA-Labortechnik, Germany) at 10,000 rpm for 5 min. Each batch of prepared emulsion weighed approximately 2 kg.
Sample B was obtained by spray drying of the prepared emulsion of fish oil and coating materials, preparation of which is described below. Skim milk powder was dissolved in cold deionized water by gentle magnetic stirring and chilled in an ice bath to 5 ± 0.5°C. An aqueous suspension of lecithin was prepared using a heated magnetic stirrer. Fish oil and lecithin suspension were poured into the prepared skim milk powder solution under stirring. Composition and preparation procedure of sample B was based on the work of Keogh et al. [10].
Sample C was Ropufa‘10’n-3 Food Powder—commercially produced microencapsulated fish oil powder obtained by fluidization bed technique, used in food industry.
Sample D was Ropufa‘30’n-3 Food Oil—commercially produced purified and stabilized fish oil used in food industry.
Compositions of all samples prepared for evaluation during study are shown in Table 1.
Spray Drying
A pilot-scale spray dryer (Nubilosa, Italy) with an atomizer nozzle of 500 μm diameter was used in the study. The drying chamber diameter was 1.5 m, the inlet and outlet air temperatures were 160 and 65 ± 2°C, respectively. Emulsions were fed into the dryer by a peristaltic pump at a flow rate of 15.0 g min−1 and an inlet pressure of 350 kPa during spraying. Obtained powders were collected in glass vessels than vacuum-packed, sealed in aluminium bags and temporarily stored at −18°C before being subjected to storage assessment (Tables 2 and 3).
Storage Treatments
Two types of prepared samples were investigated: microencapsulated fish oil powders of the same fish oil content, differed in type of coating material (samples A, B, C) and bulk fish oil (sample D). Samples were stored under two treatments: under vacuum and pervious to air, both at 5 ± 0.5°C and without exposure to light. Conditions were chosen to eliminate the influence of light and elevated temperature as additional factors promoting oxidation of fish oil besides the presence of air. Vacuum-stored samples were closed using a vacuum packaging facility (Vac Star, Switzerland) in small bags made of two-layer polyamide–polypropylene material of 90-μm thickness. In the case of samples stored in the presence of air, the bags were closed using an office stapler. Each bag contained approximately 20 g of the sample.
Sensory Evaluation
For sensory evaluation, samples (powders 1.0 g and fish oil 2.0 g) were placed in the bottom of glass containers of 40-ml capacity and covered by a thin layer of cotton to hide the contents, then the containers were covered with Petri dishes. Cotton covering was done to avoid the influence of the samples' visual appearance during the assessment. The amount of material for odor evaluation was established experimentally. Half an hour after preparation, coded (three-digit random numbers) sample sets were presented to assessors for evaluation. Samples were evaluated using two sensory methods: duo-trio test and scaling method according to ISO 6658:1988 and ISO 13299:2003, respectively [20, 21].
Discriminatory Duo-trio Test
Evaluations was performed by 30 assessors, who were trained in the basic sensory methods and selected for their ability to discriminate given differences. Four sets of samples were given to each assessor. Each set consisted of three samples: two coded (stored in the presence of air and vacuum stored) and one matched with the reference sample (vacuum stored), and an individual score sheet. Each assessor had to indicate which coded sample matched the reference. If no differences were apparent between the two unknown samples, assessors were asked to guess. Discriminatory evaluations were conducted each day until differences occurred between the samples in each set. The cut-off criterion was established counting the number of correct answers and referring to relevant statistical tables for interpretation. The test room for sensory evaluation was air-conditioned and free of disturbing factors (odors, noise, etc.).
Scaling Method
Sensory evaluation was carried by an analytical panel consisting of ten assessors with a good knowledge of sensory methodology, in particular concerning quantitative descriptive analysis. Panellists were formally trained (according to ISO 8586-2:1994) and well experienced (3–10 years of sensory evaluation practice) [22]. Odor attributes were chosen according to the QDA procedure described in ISO 13299:2003. During the preliminary session, three attributes common to all samples where chosen and their definitions agreed upon, after being discussed by the panel to ensure that the attributes were equally understood by all panelists (Table 2). Each sample was also characterized by specific attributes (“other odor”), which could be defined as an additional impression during smelling, and described in Table 3. Furthermore, the additional attribute “off-flavor” was detected during thestorage test. This was also discussed and described for each sample separately (Table 3).
The intensity of attributes was measured on a linear scale, anchored ‘‘none’’ to ‘‘very strong’’; the results were then converted to numerical values (0–10 units). For each evaluation, a set of eight coded samples (four stored in the presence of air and the relevant four vacuum stored) were given to each assessor in random order. Each assessor's booth contained instructions on the evaluation procedure. Assessors were asked to take longer breaks after the evaluation of four samples. All evaluations were made in two replications; 20 individual results were used for statistical data analysis. Two sessions were conducted per day; in the morning and then after a 4-h break. Scaling of odor attributes was conducted during 21 days of storage at 3-day intervals.
Sensory assessments were made in the sensory laboratory designed and equipped according to ISO 8589:1988 [23], in individual booths equipped with computerized systems for data acquisition. For the experimental design, sample coding and data collection, Analsens NT software was used (Polish Academy of Sciences, Warsaw, Poland).
Microscopic Evaluation
The surface appearance and morphology of fish oil powders were examined by Scanning Electron Microscopy (SEM) (XL 20 Philips, Netherlands). Samples were fixed onto double-sided adhesive carbon tabs mounted on SEM-tubs, coated with gold and palladium in a sutter coater, and examined by SEM operating at 5 kV.
Particle Size Analysis
Size analysis was carried out using the Sympatec laser light particle size analyzer (Sympatec, Germany). The sample material was put inside the measuing chamber and treated by laser light diffraction for size analysis.
Encapsulation Efficiency
This was determined by measuring the fish oil retention level in the powders. The oil retention level was based on calculating the ratio of oil content per unit mass in the powder and oil content per unit mass in the emulsion (all dry weight). Real content of fish oil in evaluated powders was estimated by Soxhlet extraction. The sample material was put into an extraction thimble, which was closed with glass wool and then placed in a Soxhlet extractor. A condenser was installed on top of the Soxhlet extractor and fed with cooling water at 2°C. The prepared round evaporation flask was filled with 75.0 ml of petrol ether and connected to the Soxhlet extractor. The petrol ether was heated to boiling point and run for 4 h. After that, petrol ether was evaporated for 30 min at 50°C. A water vacuum pump was used to accelerate the process. The evaporation flask was stored under an extraction hood for 15 min, and then the content was weighed.
Peroxide Value
Peroxide value (PV) was measured to determinate the oxidation process during storage. The applied iodometric method was carried out with chloroform and glacial acetic acid as solvents. Samples representing 0.5 g of oil were placed in the Erlenmeyer flask and dissolved in 20 ml of chloroform. Then, 30 ml of glacial acetic acid was added and the mixture was stirred for a few seconds to ensure the mixing. After that, 0.5 ml of potassium iodide solution was added. After 1 min, 30 ml of deionized water was added and the titration started. When the dark yellow color changed to a pale yellow, 0.5 ml of starch-solution was added. Titration was finished when the color disappeared. The mixture was magnetically stirred during the procedure. Results were calculated as miliequivalents of active oxygen per kilogram of fat sample (mEq).
Statistical Analysis
The results of the duo-trio sensory test were interpreted using the critical number of correct responses (P < 0.01) in a duo-trio test statistical table according to ISO 6658:1988 [20]. The results of the sensory scaling method were analyzed using one-way analysis of variance (ANOVA) to check the significance of differences in attributes intensity among samples treated differently during storage (air presence and vacuum storage). As a variability factor, sensory attributes evaluated during the tests were considered. Finally, Pearson’s correlation coefficients were calculated between the results of peroxide value and selected sensory attributes. Established significance level was P < 0.01. Results were statistically analyzed using software calculating chart MS Excel v.6 (Microsoft, USA).
Results and Discussion
Visual Observations
Samples of fish oil powders differed from each other in odor, appearance, and particles diameter. Visual observations showed that color of sample A was white, sample B pale yellowish, sample C pale brownish, and sample D yellowish. Samples A, B, and C were dry powders of different granulation. Samples A and B were fine and smooth, sample C coarse and sand-like, sample D clear oil.
Microscopy SEM
Examination under a microscope was carried out for spray-dried samples A and B, the results of which are shown in Fig. 1. Particles formed spherical structures with a void inside. Some unbound wall material occurred around the microcapsules. The surface of sample A was smooth with some erosion and small holes; sample B surface resembled a spongy structure.
Size Analysis
This revealed average diameters of sample A and B particles as 27.3 and 38.2 μm, respectively. The average diameter of sample C was much higher at 332.6 μm. In Fig. 2, an example of a particle size analysis graph interpretation is shown (sample A). Sinusoid curve reflects statistical distribution of particle size, with the highest peak indicating the average particle size. S-shaped curve reflects the percentage amount of particles of various sizes. In the case of samples A, B and C, the diameter of 50% of all particles were in the ranges 10–30, 10–40, and 200–500 μm, respectively. The diameter of the microcapsules probably depended on homogenization parameters, coating materials used and the microencapsulation conditions and technique.
Encapsulation Efficiency
The mean of encapsulation efficiency of powders A and B was 89 and 92%, respectively. This assured a fish oil content of approximately 300 g kg−1 in both samples.
Sensory Duo-trio Test
Evaluation of sample A stored in the presence of air and relevant sample stored under vacuum showed mutual differences of odor quality occurring after 6 days of storage, indicated by 26 correct answers and statistically significant (P < 0.01). A similar result was detected in the case of sample B (22 correct answers). Sample C stored in the presence of air and under vacuum showed differences of odor after 8 days of storage (24 correct answers, P < 0.01). A similar result was obtained in the case of sample D (23 correct answers). The results obtained showed that the odors of samples A and B differed more rapidly from the reference (vacuum stored) in comparison to samples C and D. Results of the duo-trio test showed a so-called sensory induction period, which was the moment when fish oil started to deteriorate.
Sensory Scaling
Results of the evaluation of the samples at the beginning of the storage test showed that sample A was characterized by the highest intensity of an “oily fish” attribute, which was twice the intensity of other samples. Intensity of the “irritating” attribute of sample A compared to samples B and C was 3.5 and 2 times higher, respectively. Sample D (bulk fish oil) was characterized by the lowest intensity of all evaluated attributes in comparison to fish oil powder samples. Sample D was the most sensory indifferent among all evaluated samples.
Intensity of odor attributes of all samples stored in the presence of air gradually changed during the test period, and was much stronger in comparison to vacuum stored ones, as shown in Fig. 3. The lowest changes of odor profile of samples stored in the presence of air were shown in sample D. The strongest changes occurred in the case of sample A. At the end of test period of the odor profile of sample A the “off-flavor” attribute was dominant together with the “irritating” one. The intensity of both attributes started to increase to a statistically significant extent after 7 days of storage, reaching 4.2 and 6.2 units, respectively (P < 0.01). In the case of sample D, a significant increase was shown only in the case of “off-flavor” attribute, which started after 15 days, reaching 1.9 units (P < 0.01). Odor profiles of vacuum stored samples A, B and C changed significantly only in the intensity of the “off-flavor” attribute, which increased statistically significantly after 15 days of storage (P < 0.01). Other attributes of these samples changed non-significantly, as did all attributes of vacuum stored sample D.
Relationship between PV and sensory scaling
Intensities of the attributes showing the highest increase during the test were correlated with the results of PV measurements of samples of the highest and lowest intensity of odor profile changes, i.e., samples A and D (Fig. 4). Coefficients of correlation were calculated for the intensity of the attribute “irritating” and PV, as well as for the intensity of the attribute “off-flavor” and PV. In the case of sample A, both calculated coefficients were positive and high (r = 0.93 and r = 0.96, respectively), i.e., there were significant correlations between PV and these attributes. In the case of other attributes, calculated coefficients of correlation were low, i.e., there were no significant correlations between PV and these attributes. Also, no correlation was shown for all attributes of sample D.
It was also shown that there is a significant influence of using coating materials on the sensory quality of evaluated fish oil powders (samples A, B and C). Materials used for the coating of sample A (methylcellulose) provoked more potent changes of fish oil odor profile than in other samples. In the case of sample C, the coating material, as well as the other microencapsulation technique, caused a higher stability in comparison to samples A and B.
Results obtained in this study indicated that stability of evaluated odor attributes differed depending on treatment during storage of samples. The most stable was bulk fish oil, while the least was spray-dried sample A. Samples B and C were unstable, although to a lesser extent than sample A. The results support our hypothesis that microencapsulation may significantly affect fish oil odor profile and will decrease its sensory and chemical stability. Moreover, the spray-drying technique provokes the strongest changes of fish oil sensory profile. A decrease of oxidative stability of fish oil powders in comparison to bulk fish oil is probably related to an increase of the surface area of powders,although its stability may be improved when stored under vacuum.
References
Connor WE (2000) Importance of n-3 fatty acids in health and disease. Am J Clin Nutr 71(S):171–175
Simopoulos AP, Leaf A, Salem N (1999) Essentiality of and recommended dietary intakes for omega-6 and omega-3 fatty acids. Ann Nutr Metab 43:127–131
Thautwein EA (2001) N−3 fatty acids—physiological and technical aspects for their use in food. Eur J Lipid Sci Technol 103:45–55
Sanders TAB (2000) Polyunsaturated fatty acids in the food chain in Europe. Am J Clin Nutr 71(S):176–181
Kolanowski W, Laufenberg G (2006) Enrichment of food products with polyunsaturated fatty acids by fish oil addition. Eur Food Res Technol 222:472–477
Jacobsen C (1999) Sensory impact of lipid oxidation in complex food systems. Fett-Lipid 101(S):484–492
Neil ME, Younger KM (1998) Microencapsulation of marine oils with a view to food fortification. In: Sadler MJ, Saltmarsh M (eds) Functional foods: the consumer, the product and the evidence. Springer, Berlin Heidelberg New York, pp 149–158
Meilgaard MC, Civille GV, Carr BT 1999 Sensory evaluation techniques, 3rd edn. CRC Press, New York
Murray JM, Delahunty CM, Baxter IA (2001) Descriptive sensory analysis: present and future. Food Res Int 34:461–471
Keogh MK, O’Kenedy BT, Kelly J, Auty MA, Kelly PM, Fureby A, Haahr AM (2001) Stability to oxidation of spray-dried fish oil powder microencapsulated using milk ingredients. J Food Sci 66:217–224
Hogan SA, O’Riordan ED, O’Sullivan M (2003) Microencapsulation and oxidation stability of spray-dried fish oil emulsions. J Microencapsul 20:675–688
Heinzelmann K, Franke K, Valesco J, Marquez-Ruiz G (2000) Protection of fish oil from oxidation by microencapsulation using freeze-drying techniques. Eur Food Res Technol 211:234–239
Kolanowski W, Ziolkowski M, Weißbrodt J, Kunz B, Laufenberg G (2006) Microencapsulation of fish oil by spray drying—impact on oxidative stability Part 1. Eur Food Res Technol 222:336–342
Lamprecht A, Schfer U, Legr CM (2001) Influences of process parameters on preparation microparticles used as a carrier system for Ω-3 unsaturated fatty acids ethyl esters used in supplementary nutrition. J Microencapsul 18:347–357
Wallace JMW, McCabe AJ, Robson PJ, Keogh MK, Murray CA, Kelly PM (2000) Bioavailability of n-3 polyunsaturated fatty acids (PUFA) in foods enriched with microencapsulated fish oil. Ann Nutr Metab 44:157–162
Rietjens IM, Boersma MG, de Haan L, Spenkelink B, Awad HM, Cnubben NHP, van Zanden JJ, van der Woude H, Alink GM, Koeman JH (2002) The prooxidant chemistry of the natural antioxidants vitamin C, vitamin E, carotenoids and flavonoids. Environ Toxicol Pharmacol 11:321–333
Let MB, Jacobsen C, Meyer AS (2003) Effects of fish oil type, lipid antioxidants, presence of rapeseed oil on oxidative flavour stability of fish oil enriched milk. Eur J Lipid Sci Technol 106:170–182
Frankel EN, Satué-Gracia T, Meyer AS, German JB (2002) Oxidative stability of fish and algae oils containing long-chain polyunsaturated fatty acids in bulk and in oil-in-water emulsions. J Agric Food Chem 50:2094–2099
Druaux C, Voilley A (1997) Effect of food composition and microstructure on volatile flavour release. Trends Food Sci Technol 8:364–368
ISO 6658:1988, Sensory analysis, methodology, general guidance
ISO 13299:2003, Sensory analysis, methodology, general guidance for establishing a sensory profile
ISO 8586-2:1994, Sensory analysis. General guidance for the selection, training and monitoring of assessors. Part 2, Experts
ISO 8589:1988, Sensory analysis, general guidance for the design of test rooms
Acknowledgments
This work was supported in part by research grant from German Academic Exchange Service. Authors thank DSM Nutritional Products for free sample of fish oil preparations. Authors also thank Georg Brener GmbH for thefree sample of methylcellulose.
Author information
Authors and Affiliations
Corresponding author
About this article
Cite this article
Kolanowski, W., Jaworska, D., Weißbrodt, J. et al. Sensory Assessment of Microencapsulated Fish Oil Powder. J Amer Oil Chem Soc 84, 37–45 (2007). https://doi.org/10.1007/s11746-006-1000-x
Received:
Accepted:
Published:
Issue Date:
DOI: https://doi.org/10.1007/s11746-006-1000-x